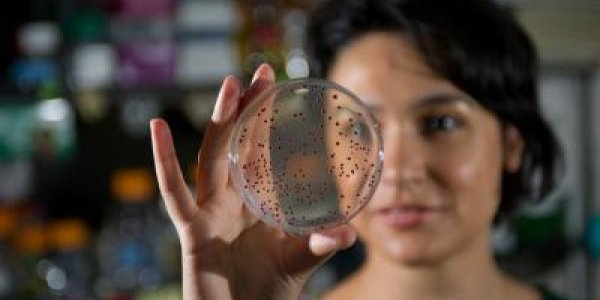
Paleo-Experimental Evolution: Resurrecting A 500-Million-Year-Old Gene

Mathematicians Solve A Mystery Of MicroRNA
Mathematicians have proposed a new solution to understanding a MicroRNA puzzle; different and sometimes conflicting theories about ways in which microRNAs regulate protein production, since the…